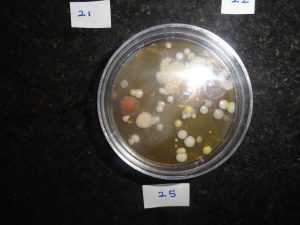
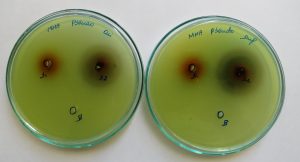
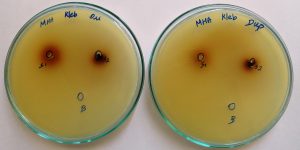
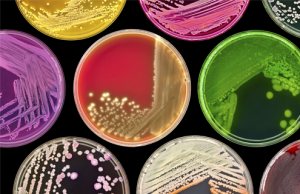

Gallery
Waste water & Water
Environmental Monitoring
Food
Soil Sludge
Microbiology
Waste water & Water
Environmental Monitoring
Food
Soil Sludge
Microbiology